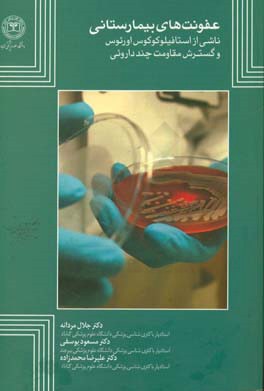
عفونت‌های بیمارستانی ناشی از استافیلوکوکوس اورئوس و گسترش مقاومت چنددارویی

توضیحات محصول
کتاب حاضر، در خصوص عفونتهاي بيمارستاني ناشي از باکتري استافيلوکوک اورئوس و گسترش مقاومت به داروهاي مختلف در اين باکتري است. در اين کتاب اطلاعات جامع و کاملي راجع به استافيلوکوک اورئوس و مقاومتهاي آنتيبيوتيکي آن ارائه شده است. اين کتاب قابلاستفاده جهت دانشجويان و اساتيد گروههاي پزشکي، پيراپزشکي، بهداشت، کنترل عفونتهاي بيمارستاني و افراد شاغل در بيمارستانها و ديگر علاقهمندان است.
مشخصات محصول
-
زبان
-
فارسی
-
وزن
-
312
-
کد دیوی
-
589.9
-
مکان انتشار
-
مشهد - خراسان رضوی
-
تعداد صفحه
-
208
-
زمان انتشار
-
1397
-
شابک
-
9786001065842
نظرات کاربران
- مرتب سازی بر اساس :
- نظر خریداران
- مفیدترین نظرات
- جدیدترین نظرات
هنوز نظری برای این محصول ثبت نشده است.

نظرات کاربران
برای ثبت نظر، از طریق دکمه ثبت نظر اقدام نمایید.
متوسط امتیازها
0.0